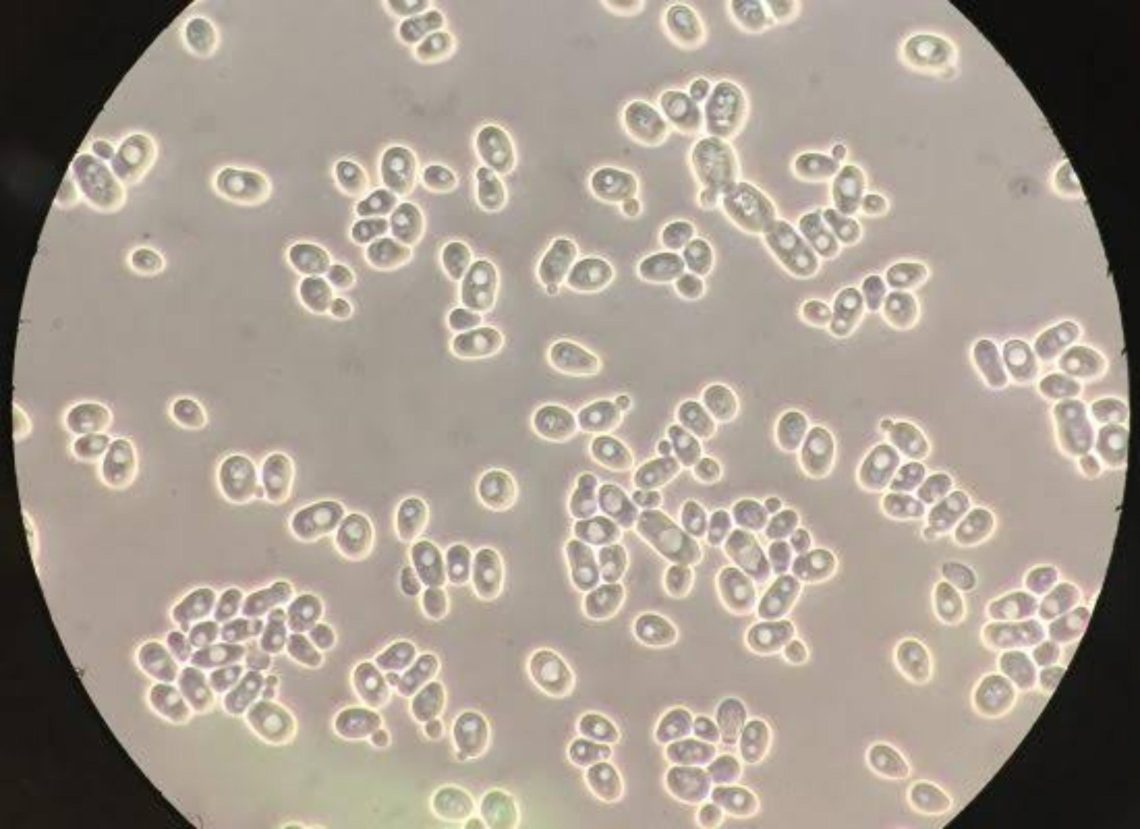

No todo en la vida de Stalin fue acero y revolución. También hubo copas… y de las buenas. El líder soviético, pese a su fama de implacable, tenía un gusto refinado por el vino, especialmente por uno que hoy es casi una leyenda: el Khvanchkara, un tinto georgiano semidulce que se convirtió en su favorito. 🍇 Origen con sabor caucásicoEl Khvanchkara procede de la región montañosa de Racha, en Georgia, tierra natal de Stalin. Se elabora con uvas Alexandrouli y Mujuretuli, autóctonas de la zona, y destaca por su equilibrio entre dulzor y frescura. Nada de burdas bebidas proletarias: este era un vino que hablaba de raíces y tradición. 🍷…
Famosos entre viñas: cuando la música, la literatura y la velocidad se sirven en copa
El vino es mucho más que una bebida: es paisaje, cultura, relato. Por eso no sorprende que actores, músicos, escritores e incluso pilotos de Fórmula 1 caigan rendidos a su encanto. Algunos se limitan a poner su nombre en la etiqueta, otros bajan al viñedo, catan barricas y se manchan las manos de mosto. Vamos a recorrer algunos casos curiosos donde la fama se mezcla con la fermentación. Valtteri Bottas: del podio a McLaren Vale El piloto finlandés de F1 ha encontrado en Australia una segunda pasión: el vino. En colaboración con Oliver’s Taranga Vineyards, lanzó IHANA Wine, un Shiraz de la región de McLaren Vale.“Ihana” en finés significa maravilloso, y la producción inicial…
Vinos biodinámicos: más allá de lo ecológico
En los últimos años la viticultura biodinámica ha captado la atención de viticultores y consumidores por igual. No se trata solo de evitar químicos, sino de concebir el viñedo como un organismo vivo, en armonía con el entorno, los ciclos naturales y, para muchos, con influencias cósmicas. ¿Qué son los vinos biodinámicos? ¿Cómo se elaboran? Prácticas esenciales Estas son algunas de las prácticas más frecuentes o definitorias: Beneficios, críticas y desafíos Anécdotas y ejemplos curiosos Conclusión El vino biodinámico no es solo una moda: representa una propuesta que busca reconectar al viticultor con su tierra, con los ciclos naturales, con una filosofía que exige respeto, paciencia y humildad frente al…
Cata de Mundovino.net: Himen
Bodega: Loxarel D.O./Zona: D.O.Penedes Variedades: 100%Xarelo Elaboración: Vino de crianza biológica de viticultura ecológica y biodinámica. Fermentación: En ánforas de barro sin control de temperatura, con levaduras autóctonas. Crianza: Bajo velo de flor (crianza biológica) en ánfora durante varios meses, lo que aporta ese perfil salino y punzante, cercano a los vinos andaluces. Intervención mínima: Sin filtrado, sin clarificado, y con muy poco o ningún sulfuroso añadido. Cata: Vista 👁️ Color amarillo dorado, limpio y brillante, con reflejos ambarinos que anticipan cierta evolución. Lágrima fina y persistente, muestra densidad en copa. Nariz 👃 Intensa y compleja desde el primer momento. Notas punzantes y salinas propias del velo de flor: frutos…
Cata de Mundovino.net: Rodríguez & Sanzo – Bajo Velo Verdejo 2022
Bodega: Bodega Rodríguez & Sanzo Denominación: D.O. Rueda Variedad: 100% Verdejo Elaboración: Crianza bajo velo de flor Cata: Vista Color amarillo dorado brillante con reflejos pajizos intensos. Se muestra limpio y luminoso. Nariz En nariz es complejo y elegante. Aparecen notas de manzana asada , recuerdos de frutos secos como almendra y avellana , y un fondo de panadería y levadura de flor que delata su crianza bajo velo. Con la aireación surgen matices de heno seco y camomila , junto a toques de piel de limón confitada y un sutil carácter salino . Boca En boca tiene una entrada seca y envolvente, con textura glicérica que llena el paladar. Su paso es sabroso y equilibrado, donde destacan los cítricos maduros , los frutos secos y un marcado carácter mineral . El final es largo,…
Altanza Crianza 2021 | EDULIS Crianza, elegido entre los Top 100 Best Buy Wines 2025 por Wine Enthusiast
Fuenmayor, 17 de septiembre de 2025. – Bodegas Altanza celebra un nuevo hito en su trayectoria:su vino Altanza Crianza 2021 (100% Tempranillo, Rioja) ha sido seleccionado por la prestigiosarevista estadounidense Wine Enthusiast como uno de los Top 100 Best Buy Wines 2025, alcanzandoel puesto #49 con 92 puntos. Este reconocimiento internacional pone en valor el compromiso de Altanza con la calidad, laautenticidad y la tradició n riojana, acercando al mundo vinos que combinan elegancia, frescura ytipicidad. «En cada cosecha buscamos un Crianza que muestre fruta viva, un toque de chocolate, taninos jugososy un /inal sabroso. Es la esencia de nuestro Tempranillo y de Rioja. El trabajo de todo el añ…
MOËT & CHANDON CELEBRA LA VENDIMIA:UN LEGADO DE EXCELENCIA Y ‘SAVOIR-FAIRE’
En el corazón de Champagne, Moët & Chandon da la bienvenida y abre las puertas a la vendimia, un momento culminante que define la excelencia y el savoir-faire de la Maison. Cada año, este período crucial marca el inicio de la creación de sus icónicos champagnes, uniendo tradición, innovación y tecnología de vanguardia en un proceso meticuloso que honra el legado de Moët & Chandon. La vendimia en Moët & Chandon es una ventana al alma de la Maison, un testimonio del trabajo colectivo y el compromiso que la han convertido en un símbolo mundial de elegancia y celebración. Desde los viñedos bañados por el sol hasta las bodegas donde el tiempo y…
AIRÉN REVOLUTION: LA QUE FUERA UVA MÁS PLANTADA DEL MUNDO, SE REINVIDICA CON WINE UP!
Dos catas monográficas en Socuéllamos y Tomelloso con distintas elaboraciones de la de la variedad Airén para conocer la versatilidad de esta uva. El sábado 13 de septiembre se celebró en La Cueva de God Save the Wine una cata muy especial bajo el título “Make Airén Great Again – Airén Revolution”, dirigida por Joaquín Parra, autor de la guía de vinos y destilados Wine Up!. Una cata réplica de la celebrada el pasado 15 de agosto en el Museo Torre del Vino de Socuéllamos patrocinada por la concejalía de turismo de la localidad. Encuentros que reunieron a un selecto grupo de profesionales y aficionados al vino con un objetivo…
PRADOREY, ENTRE LAS BODEGAS MÁS SOSTENIBLES DE ESPAÑA
En España, solo 110 de las 4.000 bodegas que hay cuentan con el certificado de Sustainable Wineries for Climate Protection (SWfCP), la de Gumiel de Mercado entre ellas; sumándose al reducido grupo que lideran el camino hacia un sector vitivinícola más sostenible, competitivo y responsable Esta certificación reconoce que en Pradorey trabajan de forma responsable para reducir su impacto en el medio ambiente, con mejoras en áreas como consumo energético, gestión del agua y de residuos o emisiones de CO₂ Además, SWfCP es el único sello específico para el sector vitivinícola en nuestro país queavala una gestión sostenible real y medible, no solo en el ámbito ambiental,…
Gin MG x Putos Modernos: Vuelta a la rutina. Pero esta vez, además de gin, hielo y tónica, trae un poco de humor.
Barcelona, septiembre 2025 – Septiembre vuelve con todo: el despertador, los emails sin leer, la agenda llena y ese clásico momento existencial frente al tupper del lunes. Desde Gin MG lo tenemos claro: la rutina no se combate, se brinda. Y si es con una copa bien servida (y sentido del humor), mucho mejor. Por eso, Gin MG se une a Putos Modernos en una colaboración que pone el foco donde otros no miran: en lo cotidiano. En esos días que no salen en Pinterest, pero que también merecen un brindis. Con verdades como:“No hace falta que la tomes en un rooftop de Londres. Puedes saborearla viendo el skyline de…
Levaduras autóctonas o indígenas del vino
¿Qué son? Las levaduras autóctonas (también llamadas indígenas, nativas, salvajes) son aquellas comunidades de hongos microscópicos que viven de forma natural en los viñedos, sobre la piel de la uva, en el ambiente vegetal, en los suelos y, a veces, también dentro de las propias instalaciones de la bodega. No son introducidas artificialmente, sino que acompañan al mosto desde que la uva comienza su transformación. Contrastan con las levaduras comerciales (“inóculos”, cepas seleccionadas) que suelen agregarse para asegurar fermentaciones más limpias, más rápidas o más previsibles. ¿Por qué importan? 1. Marca del terruño Las levaduras autóctonas contribuyen al perfil sensorial del vino: aromas, sabores, texturas que dependen del viñedo, del…
CAMPO VIEJO RINDE HOMENAJE A LOS VENDIMIADORES CON UN PAÑUELO DE EDICIÓN LIMITADA DISEÑADO POR ROMUALDA
Con la vendimia como telón de fondo, Campo Viejo y Romualda se unen para transformar un símbolo histórico en una pieza de arte contemporáneo que honra a quienes, con esfuerzo y pasión, hacen posible cada cosecha. Logroño. 16 de septiembre de 2024.- Campo Viejo, bodega emblemática y referente de la D.O.Ca. Rioja, reafirma una vez más su profundo compromiso con la tradición y con la Pasión que despierta la vendimia. En esta ocasión lo hace de la mano de Romualda, prestigioso estudio de diseño que, con su inconfundible estilo contemporáneo, eleva lo cotidiano a la categoría de arte, reinterpretando con delicadeza y sensibilidad los símbolos que nos conectan con nuestras raíces a…